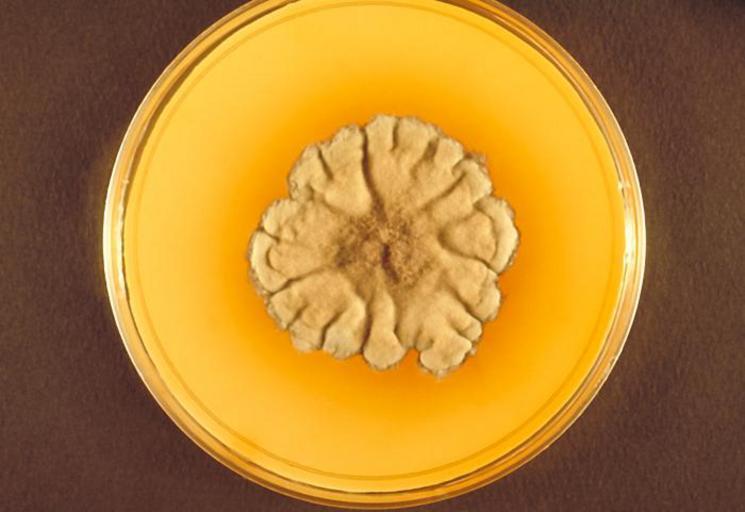

MAKE A MEME
View Large Image
| View Original: | Madurella_grisea_PHIL_4158_lores.jpg (700x481) | |||
| Download: | Original | Medium | Small | Thumb |
| Courtesy of: | commons.wikimedia.org | More Like This | ||
| Keywords: Madurella grisea PHIL 4158 lores.jpg This image shows a plate culture growing the fungus Madurella grisea Georgia isolate Some Madurella spp are a cause of mycetoma a fungal infection characterized by sclerotia or large black masses of hyphae The fungus enters the human body via trauma which usually affects the foot This disease process may take several years Content Providers s CDC/Dr Libero Ajello Creation Date 1970 Copyright Restrictions None - This image is in the public domain and thus free of any copyright restrictions As a matter of courtesy we request that the content provider be credited and notified in any public or private usage of this image http //phil cdc gov/phil_images/20030716/45/PHIL_4158_lores jpg PD-USGov Madurella grisea Petri dishes cultures | ||||